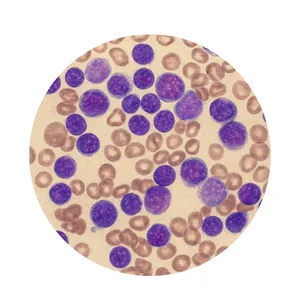

Chronic myeloid leukemia is a slow-growing blood cancer where the bone marrow produces too many abnormal white blood cells over time.
KMH Leukemia Clinic, Kilpauk, is a state-of-the-art center dedicated to advanced, patient-centered care for blood cancers. Established with the mission to provide comprehensive leukemia and lymphoma treatment, we combine expert medical guidance with the latest therapies and innovative approaches to address the unique healthcare needs of each patient. Whether you are seeking diagnosis, treatment planning, or ongoing care, our team is committed to delivering compassionate, personalized support at every stage of your journey toward better health.
4.7 Star Rating
4.7 Star Rating
Advanced diagnostics accurately identify leukemia types, enabling faster treatment planning and improving long-term patient outcomes effectively.
At VS Hospital, we combine advanced medical technology with compassionate care. Our team of expert doctors ensures accurate diagnosis, personalized treatment, and faster recovery for every patient.
Chemotherapy is a cancer treatment using powerful drugs to destroy rapidly dividing cancer cells, often causing side effects like nausea and fatigue.
Targeted therapy uses drugs to specifically attack cancer cells by focusing on molecules involved in cancer growth, sparing healthy cells.
Immunotherapy boosts the body’s immune system to recognize and destroy cancer cells, improving the body’s natural defense against various cancers.
Induction therapy is the first intensive treatment phase aimed at rapidly reducing cancer cells, achieving remission, especially in leukemia and lymphoma cases.
Consolidation therapy follows induction therapy to eliminate remaining cancer cells, strengthen remission, and prevent relapse, commonly used in leukemia and lymphoma treatment.
Maintenance therapy uses lower-dose treatments over time to keep cancer in remission, prevent relapse, and manage disease with fewer side effects.
Supportive therapy helps manage cancer treatment side effects, improves quality of life, and supports patient health, including pain relief and infection prevention.
Bone Marrow Transplant (BMT) or Hematopoietic Stem Cell Transplant (HSCT) replaces damaged bone marrow with healthy cells to treat blood cancers.
Experience advanced precision and safe recovery with Bone Marrow Transplant care. Our expert specialists ensure accuracy, protection, and long-term health restoration.
Acute myeloid leukemia is a fast-growing cancer of the blood and bone marrow, causing abnormal white blood cell production.
Acute lymphoblastic leukemia is a fast-progressing cancer where the bone marrow produces too many immature lymphocytes, disrupting normal blood cell function.
Acute promyelocytic leukemia is a subtype of acute myeloid leukemia where abnormal promyelocytes accumulate, causing bleeding, anemia, and infection risks.
Chronic myeloid leukemia is a slow-growing blood cancer where the bone marrow produces too many abnormal white blood cells over time.
Chronic lymphocytic leukemia is a slow-progressing cancer where the bone marrow produces excess abnormal lymphocytes, weakening the immune system and causing fatigue.
MD DM ( Hematology )
MD DM ( Medical Oncology)
MBBS DCP. Pathologist and Director Cell Therpay
M.Sc . Ph.D ( Flow Cytometry )
KMH Leukemia Clinic, Kilpauk, is a state-of-the-art center dedicated to advanced, patient-centered care for blood cancers. Established with the mission to provide comprehensive leukemia and lymphoma treatment, we combine expert medical guidance with the latest therapies and innovative approaches to address the unique healthcare needs of each patient. Whether you are seeking diagnosis, treatment planning, or ongoing care, our team is committed to delivering compassionate, personalized support at every stage of your journey toward better health.
Acute myeloid leukemia is a fast-growing cancer of the blood and bone marrow, causing abnormal white blood cell production.
Acute lymphoblastic leukemia is a fast-progressing cancer where the bone marrow produces too many immature lymphocytes, disrupting normal blood cell function.
Acute promyelocytic leukemia is a subtype of acute myeloid leukemia where abnormal promyelocytes accumulate, causing bleeding, anemia, and infection risks.
Chronic myeloid leukemia is a slow-growing blood cancer where the bone marrow produces too many abnormal white blood cells over time.
Chronic lymphocytic leukemia is a slow-progressing cancer where the bone marrow produces excess abnormal lymphocytes, weakening the immune system and causing fatigue.
Chemotherapy is a cancer treatment using powerful drugs to destroy rapidly dividing cancer cells, often causing side effects like nausea and fatigue.
Targeted therapy uses drugs to specifically attack cancer cells by focusing on molecules involved in cancer growth, sparing healthy cells.
Immunotherapy boosts the body’s immune system to recognize and destroy cancer cells, improving the body’s natural defense against various cancers.
Induction therapy is the first intensive treatment phase aimed at rapidly reducing cancer cells, achieving remission, especially in leukemia and lymphoma cases.
Consolidation therapy follows induction therapy to eliminate remaining cancer cells, strengthen remission, and prevent relapse, commonly used in leukemia and lymphoma treatment.
Maintenance therapy uses lower-dose treatments over time to keep cancer in remission, prevent relapse, and manage disease with fewer side effects.
Supportive therapy helps manage cancer treatment side effects, improves quality of life, and supports patient health, including pain relief and infection prevention.
Bone Marrow Transplant (BMT) or Hematopoietic Stem Cell Transplant (HSCT) replaces damaged bone marrow with healthy cells to treat blood cancers.
We provide a wide range of medical services to meet the needs of every patient.